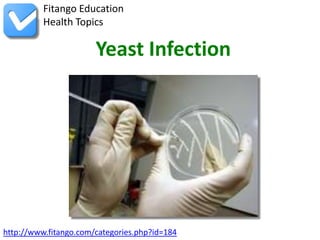

Vaginal yeast infections, commonly caused by the fungus Candida albicans, present symptoms like itching, burning, abnormal discharge, and irritation. Diagnosis involves a pelvic examination to observe symptoms and potentially take vaginal discharge for testing, while various antifungal treatments are available for management. Prevention includes maintaining hygiene, avoiding douching, and keeping the genital area dry.